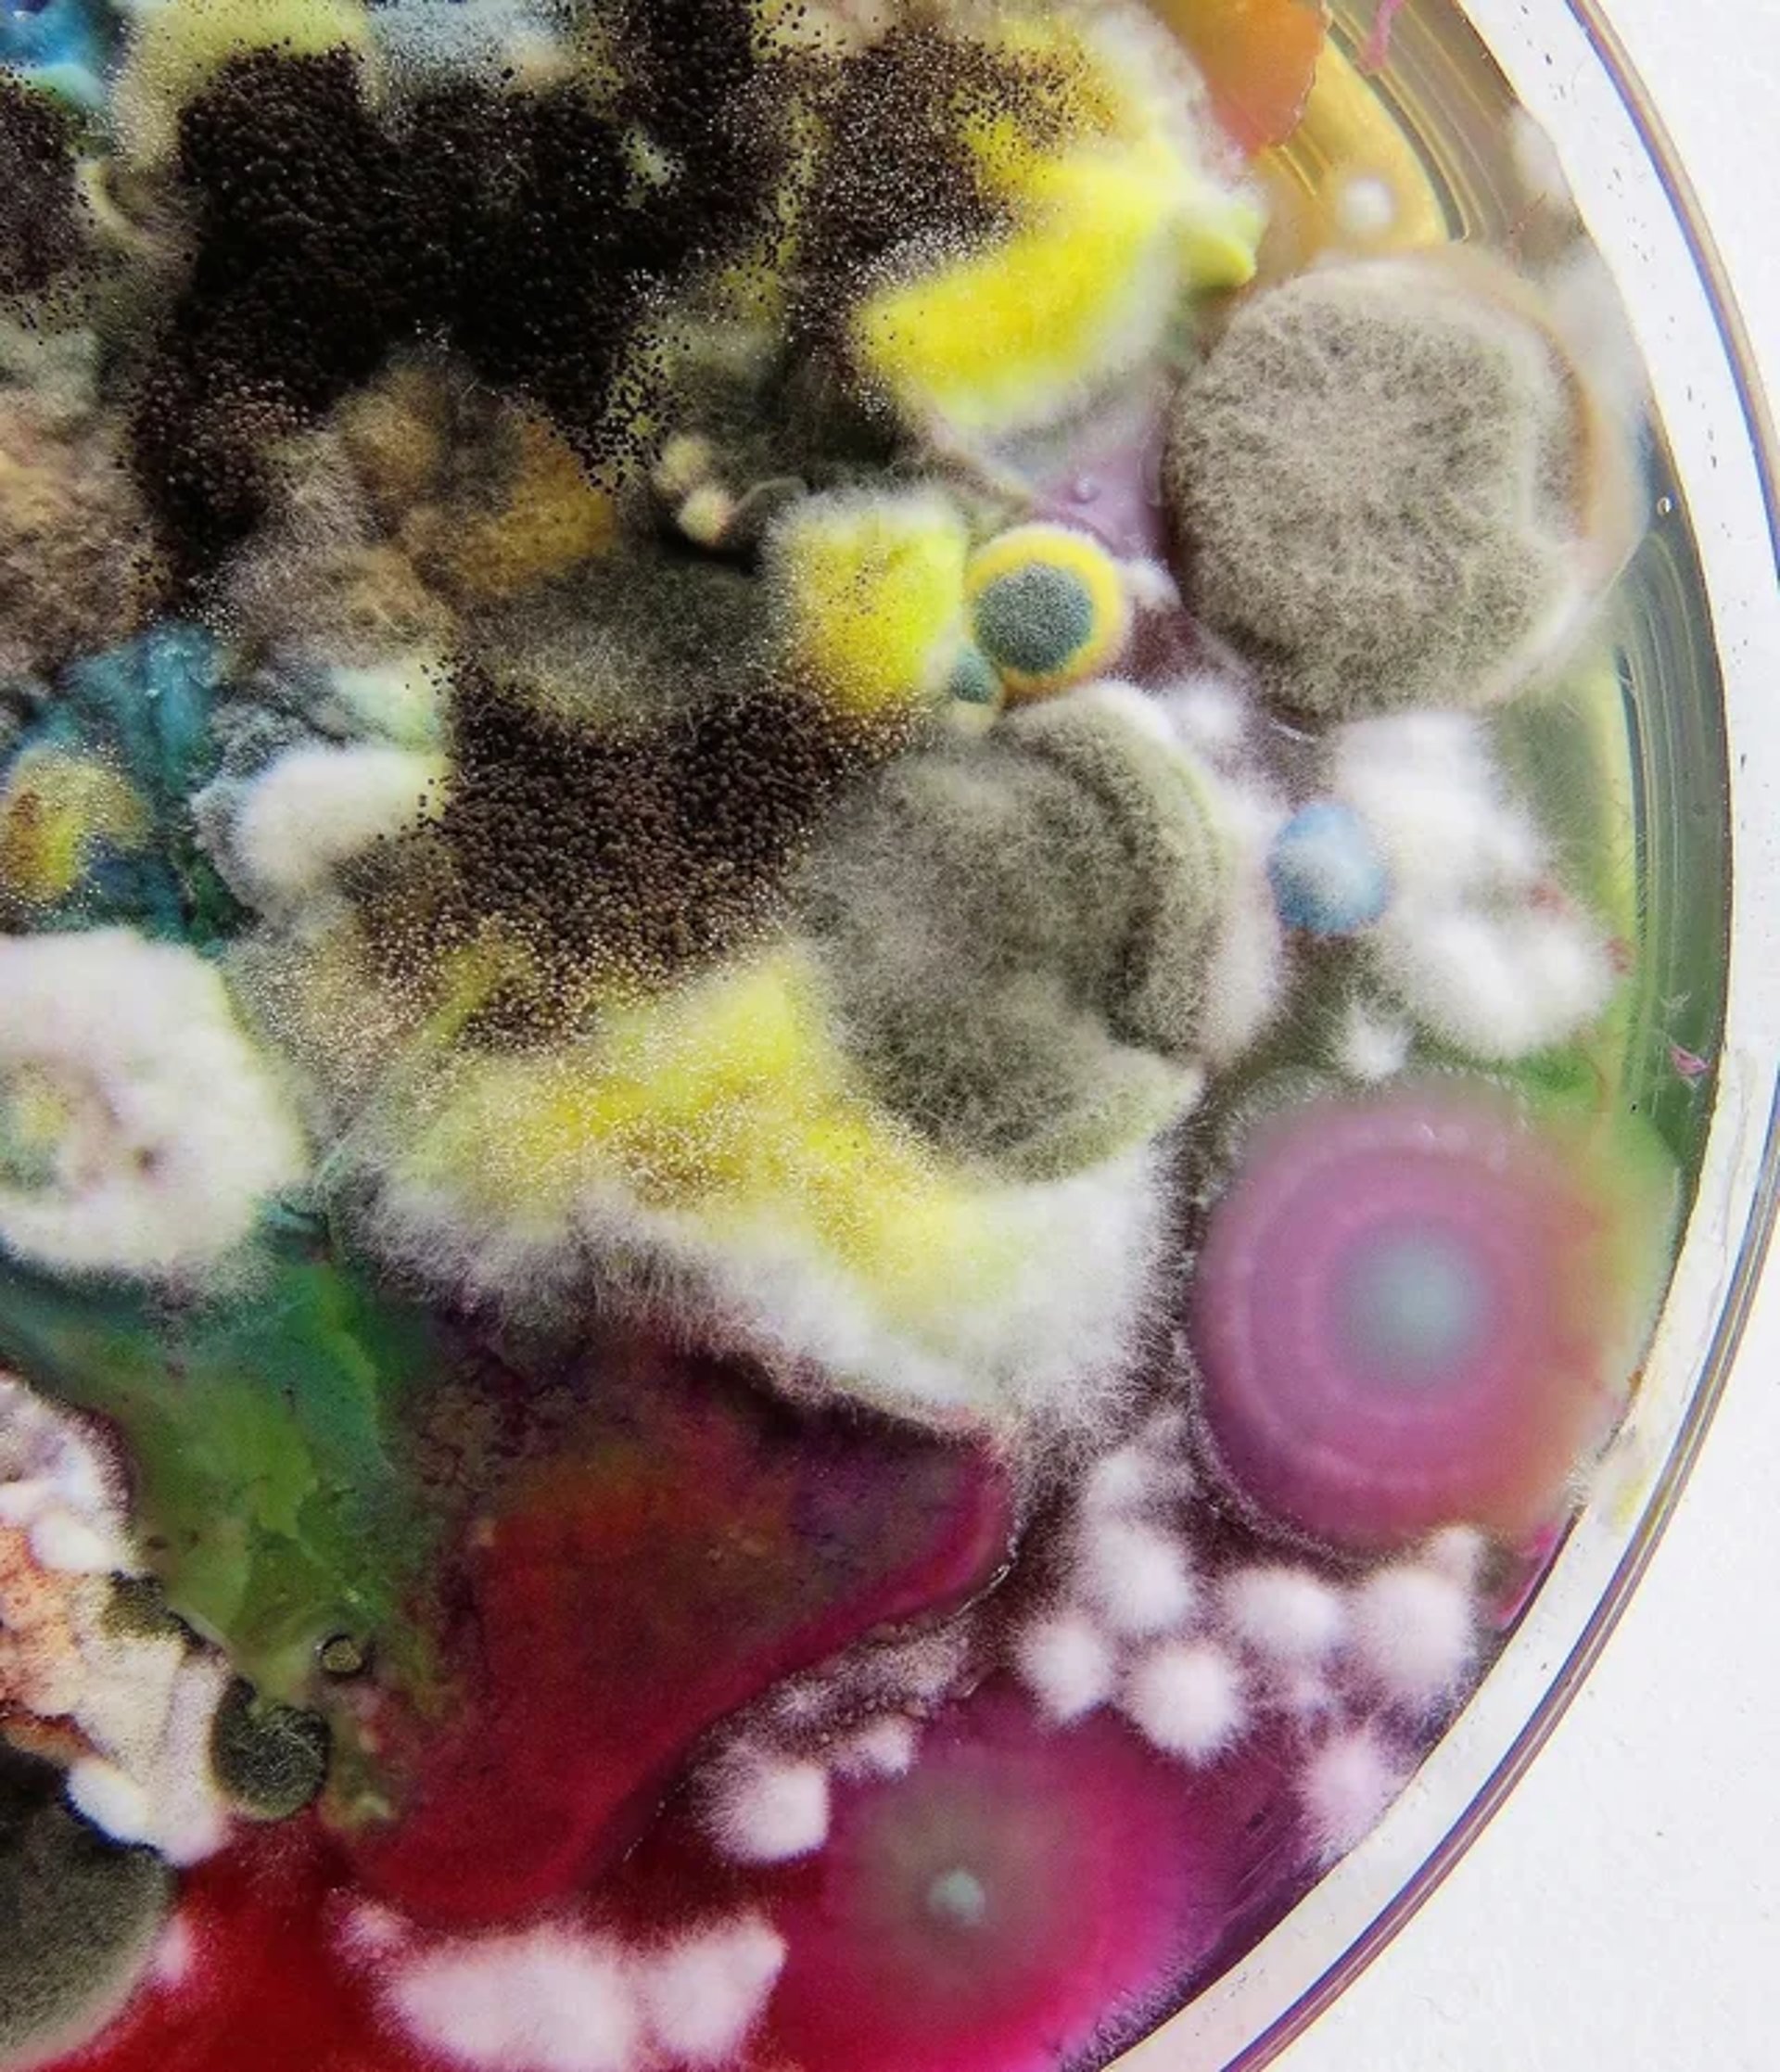
black and white bed linen

Things Voters Should Know
Normalcy bias: believing things are normal despite evidence to the contrary
Get in Touch
Questions or tips? Reach out to fungusamungus.blog anytime.
contact@fungusamungus.blog
FungusAmungus.Blog
Informed voters make stronger communities.
© 2026. FungusAmungus.Blog - All rights reserved.

